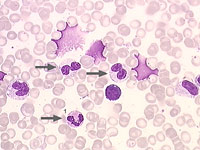

Abb. 1: Der Pfeil unten zeigt auf einen normal granulierten Granulozyten, darüber liegen zwei Zellen, die völlig agranulär sind, welche sich im Stadium zwischen Metamyelozyt und Stabkerniger befinden.
Optisch ungranulierte Granulozyten können durch einen Färbefehler des Präparates bedingt sein oder ein biologisches Phänomen darstellen, welches für Dysplasie kennzeichnend ist. Man benötigt daher einen normal granulierten Granulozyten als Vergleich, der einem zeigt, ob die Färbung zumindest an dieser Stelle gut funktioniert hat. Daraus kann ggf. der Schluss gezogen werden, dass es sich um ein biologisches Phänomen handelt. Es ist mitunter aber schwer, einen normal granulierten Granulozyten zu finden, wenn die Zellreihe dysplastisch ist.